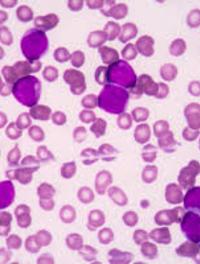

Maladie de Vaquez : l’espoir d’une espérance de vie normale grâce à l’interféron
Les patients atteints de polyglobulie de Vaquez (PV) ont eu une durée de vie diminuée du fait de complications thrombotiques parfois [...]

Les syndromes myélodysplasiques (SMD) constituent un groupe hétérogène d’hémopathies caractérisées par une dysplasie de la moelle osseuse [...]

Les syndromes myélodysplasiques (SMD) de faible risque correspondent aux catégories risque faible et risque intermédiaire 1 de l’IPSS [...]

Jusqu'à présent les tentatives d'amélioration de la survie des patients atteints de LMA par instauration d'un traitement de consolidation [...]

Les taux de guérison des enfants, adolescents et jeunes adultes atteints de leucémie lymphoblastique aiguë (LLA) se sont beaucoup améliorés [...]

L'impact positif du triplet carfilzomib/dexaméthasone/daratumumab (KdD) en cas de myélome multiple en rechute ou réfractaire (MMRR) [...]

Le bon vieil adage « Le mieux est l'ennemi du bien » se vérifie avec les tentatives d'augmentation de l'efficacité de la prévention [...]

L'anticorps monoclonal anti-CD20 recombinant humain obinutuzumab (OBI) est indiqué en association au chlorambucil (CHL) pour le traitement [...]

L'étude randomisée contrôlée de phase 3 HOPE a évalué l'impact du voxelotor versus placebo sur le cours évolutif de la drépanocytose [...]

Le cocktail bortezomib/thalidomide/dexaméthasone (VTd) est le standard de traitement des myélomes multiples nouvellement diagnostiqués [...]

Chez les patients qui vont bénéficier d’une chirurgie cardiaque, il n’est pas rare de constater une anémie plus ou moins profonde. [...]
Les patients de plus de 65 ans atteints de leucémie aigüe myéloïde (LAM) répondent souvent mal à une chimiothérapie d’induction du [...]

Le lymphome à cellules du manteau (LCM) est un lymphome B caractérisé par une translocation t(11;14) qui conduit à une hyperexpression [...]

Chez les patients de plus de 65 ans en 1ère ligne de traitement pour une leucémie lymphoïde chronique (LLC), la chimio-immunothérapie [...]

L’incidence de la leucémie aiguë myéloïde (LAM) augmente avec l’âge avec un âge médian au diagnostic d’environ 70 ans. Le pronostic [...]

Tisagenlecleucel est un traitement par cellules T porteuses d’un récepteur antigénique chimérique (CAR) qui cible le CD19. Ce traitement [...]

L’ABVD est le traitement classique de première intention des stades III et IV du lymphome de Hodgkin. Cependant 30 % des patients sont [...]

Le développement des inhibiteurs de la tyrosine-kinase (ITK) dans le traitement de la leucémie myéloïde chronique (LMC) a permis aux [...]

La myélofibrose (MF) est une néoplasie hématologique caractérisée par une anémie, une hématopoïèse extra-médullaire, une splénomégalie, [...]

La survie du myélome s’est considérablement améliorée ces dernières années avec les inhibiteurs du protéasome et les immunomodulateurs [...]
Depuis les années 1980, le « 7+3 » (aracytine 7 jours + daunorubicine 3 jours) est le standard du traitement d’induction de la leucémie [...]

Le traitement du myélome multiple a évolué depuis 15 ans avec, notamment, l’introduction des inhibiteurs du protéasome et des trithérapies [...]

Elthrombopag est un agoniste du récepteur de la thrombopoïétine (facteur de croissance de la lignée mégacaryocytaire), actif par voie [...]

Cent millions de personnes dans le monde souffrent de drépanocytose. Le mécanisme physiopathologique de la vaso-occlusion est complexe, [...]

La Polyglobulie de Vaquez (PV) est un syndrome myéloprolifératif chronique chromosome -Philadelphie négatif caractérisé par une augmentation [...]